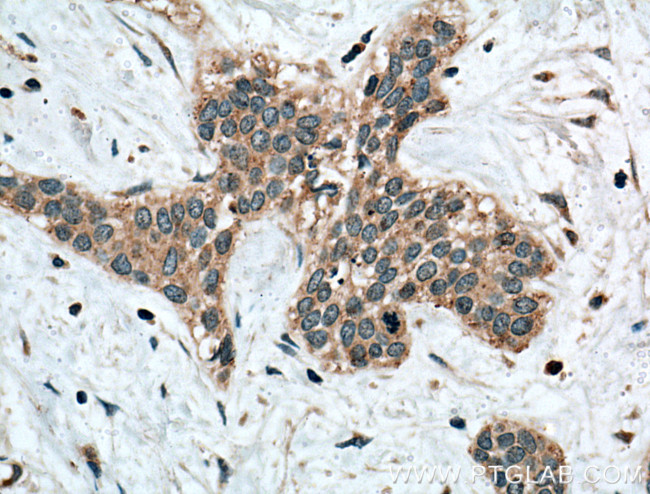
Calpain 3 Antibody in Immunohistochemistry (Paraffin) (IHC (P))

Search
Proteintech
Calpain 3 Polyclonal Antibody
{{$productOrderCtrl.translations['antibody.pdp.commerceCard.promotion.promotions']}}
{{$productOrderCtrl.translations['antibody.pdp.commerceCard.promotion.viewpromo']}}
{{$productOrderCtrl.translations['antibody.pdp.commerceCard.promotion.promocode']}}: {{promo.promoCode}} {{promo.promoTitle}} {{promo.promoDescription}}. {{$productOrderCtrl.translations['antibody.pdp.commerceCard.promotion.learnmore']}}
产品信息
10415-1-AP
种属反应
宿主/亚型
分类
类型
抗原
偶联物
形式
浓度
规格
纯化类型
保存液
内含物
保存条件
运输条件
产品详细信息
Immunogen sequence: MEICADELK KVLNTVVNKH KDLKTHGFTL ESCRSMIALM DTDGSGKLNL QEFHHLWNKI KAWQKIFKHY DTDQSGTINS YEMRNAVNDA GFHLNNQLYD IITMRYADKH MNIDFDSFIC CFVRLEGMFR AFHAFDKDGD GIIKLNVLEW LQLTMYA (1-156 aa encoded by BC003521)
靶标信息
Calpain, an intracellular calcium-dependent protease that cleaves cytoskeletal and submembranous proteins, plays a role in cytoskeletal reorganization and muscle protein degradation. Calpain is a heterodimer composed of a small regulatory subunit and one of three large catalytic subunits, designated calpain 1, calpain 2 and calpain 3. Calpain 3 (calpain p94) is a muscle-preferred calcium activated neutral protease that localizes to the nucleus. Mutations involving the calpain 3 gene are associated with limb-girdle muscle dystrophy type 2A, a form of autosomal recessive and progressive neuromuscular diso4. Calpastatin regulates calpain by inhibiting both the proteolytic activity of calpain and its binding to membranes. Calpastatin exists in two types, tissue type and erythrocyte type, resulting from both alternative splicing and proteolytic processing.
仅用于科研。不用于诊断过程。未经明确授权不得转售。
篇参考文献 (0)
生物信息学
蛋白别名: calcium dependent cysteine protease; Calcium-activated neutral proteinase 3; calpain 3 (p94) isoform CAPN3_1; calpain 3 (p94) isoform CAPN3_2; calpain 3 (p94) isoform CAPN3_7; Calpain L3; Calpain p94; calpain p94, large [catalytic] subunit; calpain, large polypeptide L3; Calpain-3; CANP 3; CAPN 3; cysteine protease; hMp78; cysteine protease; hMp84; LGMD 2A; MGC10767; MGC11121; MGC14344; MGC4403; Muscle-specific calcium-activated neutral protease 3; muscle-specific calcium-activated neutral protease 3 large subunit; nCL-1; New calpain 1; skeletal muscle specific calpain p94; unnamed protein product
基因别名: AI323605; CANP3; CANPL3; Capa-3; Capa3; CAPN3; LGMD2; LGMD2A; LGMDD4; LGMDR1; Lp82; Lp84; Lp85; nCL-1; NCL1; p94
UniProt ID: (Human) P20807, (Mouse) Q64691, (Rat) P16259
Entrez Gene ID: (Human) 825, (Mouse) 12335, (Rat) 29155